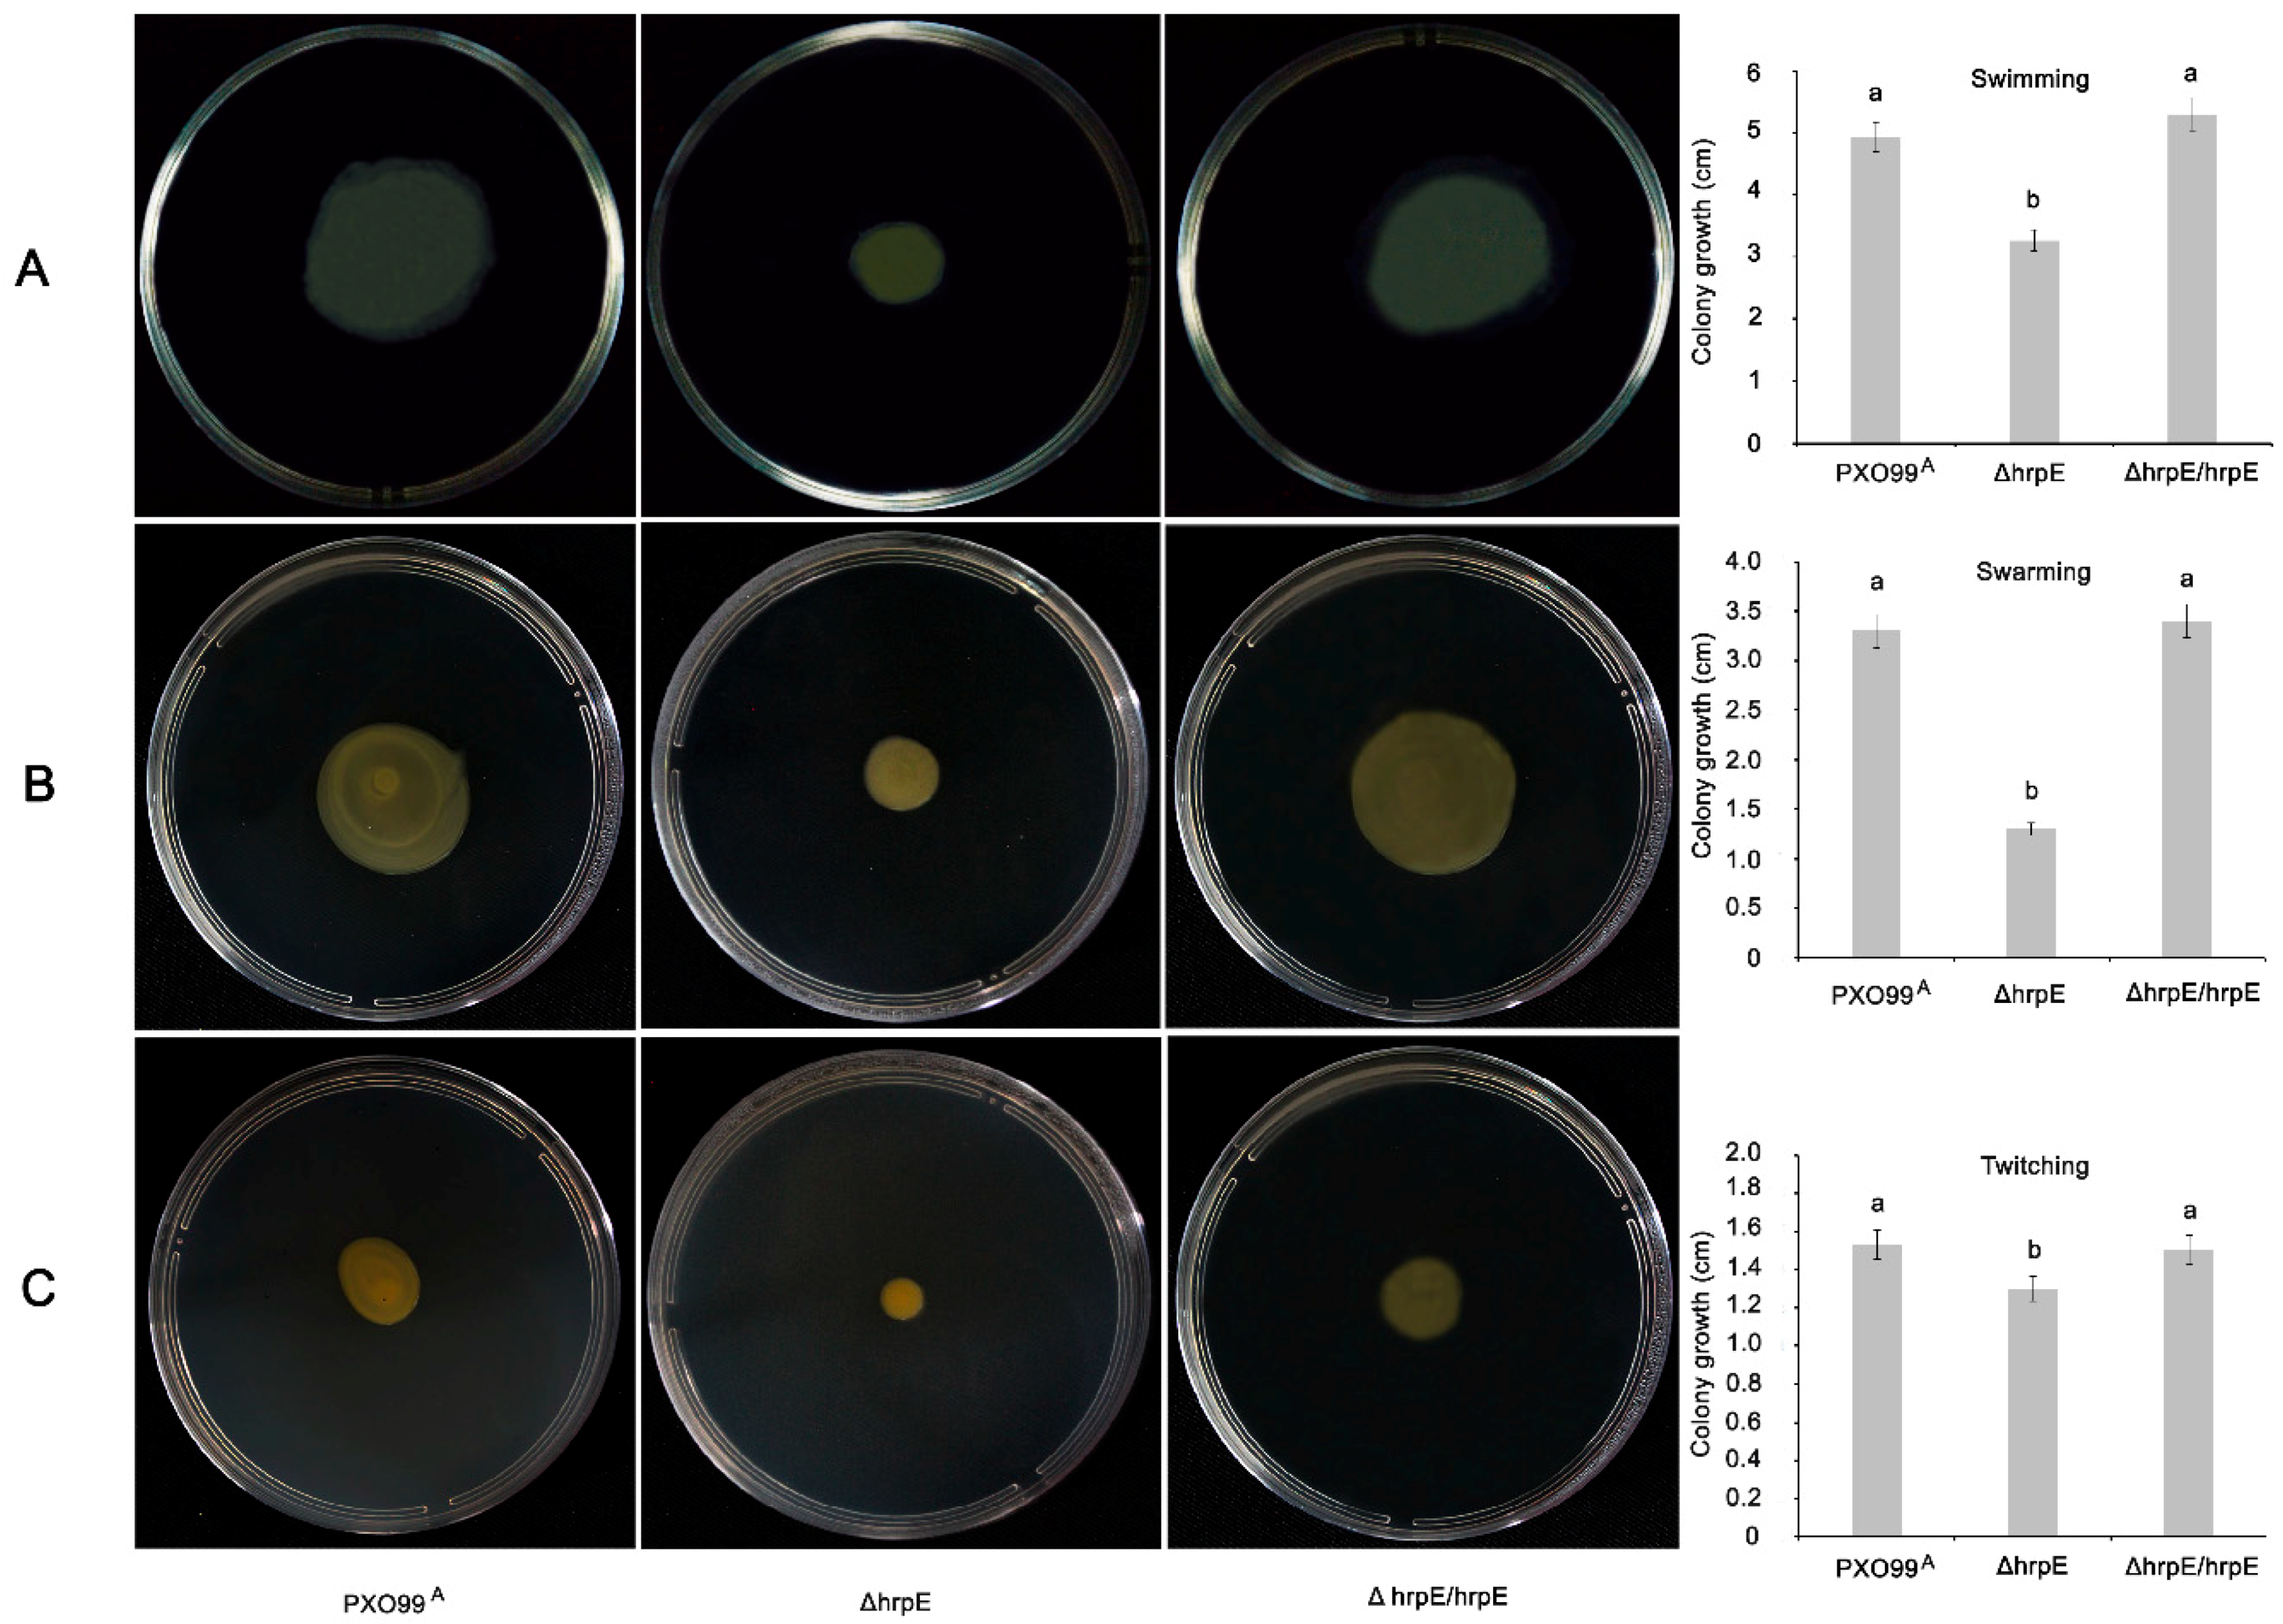
Microorganisms 07 00572 g002 Microorganisms 07 00572 g002

The Type III Accessory Protein HrpE of Xanthomonas oryzae pv. oryzae Surpasses the Secretion Role, and Enhances Plant Resistance and Photosynthesis
Abstract
1. Introduction
2. Materials and Methods
2.1. Bacterial Strains, Growth Conditions and Antibodies
2.2. Bacterial Gene Alterations
2.3. Growth Curves
2.4. Bacterial Motility Assays
2.5. In-Planta Growth Asssay
2.6. Bacterial Virulence Evaluation
2.7. Translocation Assays
2.8. Expression and Purification of Recombinant Proteins
2.9. Callose Staining
2.10. Accumulation of H2O2
2.11. Xoo Growth in Rice Leaves Pretreated with HrpE
2.12. Expression Analysis of Defense-Related Genes in Rice
2.13. Photosynthetic Activity, Transpiration Rate and Stomatal Conductance of the Rice Plant
2.14. Statistical Analysis
3. Results
3.1. HrpE Gene Deletion Affects the Growth and Colony Forming Units (CFUs)
3.2. Deletion of hrpE Affects the Bacterial Motility
3.3. Deletion of hrpE Affects the Pathogen Virulence in a Host and the Hypersensitive Response in a Non-Host
3.4. HrpE Pilus Serves as Conduit for Effector Translocation
3.5. Defense Responses Triggered by HrpE Protein
3.6. Pre-Treatment of Rice Leaves with HrpE Supresses Xanthomonas oryzae pv oryzae (Xoo) Growth
3.7. Expression Profiling of the Plant Defense Related Genes under the Influence of HrpE
3.8. Pre-Treatment with HrpE Influences the Photosynthetic Activity, Transpiration Rate and Stomatal Conductance of the Rice Plant
4. Discussion
Supplementary Materials
Author Contributions
Funding
Conflicts of Interest
References
- Büttner, D.; Bonas, U. Port of entry-the type III secretion translocon. Trends Microbiol. 2002, 10, 186–192. [Google Scholar] [CrossRef]
- Alfano, J.R.; Collmer, A. Type III secretion system effector proteins: Double agents in bacterial disease and plant defense. Annu. Rev. Phytopathol. 2004, 42, 385–414. [Google Scholar] [CrossRef] [PubMed]
- Blocker, A.; Komoriya, K.; Aizawa, S.-I. Type III secretion systems and bacterial flagella: Insights into their function from structural similarities. Proc. Natl. Acad. Sci. USA 2003, 100, 3027–3030. [Google Scholar] [CrossRef] [PubMed]
- Giltner, C.L.; Nguyen, Y.; Burrows, L.L. Type IV pilin proteins: Versatile molecular modules. Microbiol. Mol. Biol. Rev. 2012, 76, 740–772. [Google Scholar] [CrossRef] [PubMed]
- Aizawa, S.I. Bacterial flagella and type III secretion systems. FEMS Microbiol. Lett. 2001, 202, 157–164. [Google Scholar] [CrossRef] [PubMed]
- Buttner, D.; He, S.Y. Type III protein secretion in plant pathogenic bacteria. Plant Physiol. 2009, 150, 1656–1664. [Google Scholar] [CrossRef] [PubMed]
- Hienonen, E.; Roine, E.; Romantschuk, M.; Taira, S. Taira mRNA stability and the secretion signal of HrpA, a pilin secreted by the type III system in Pseudomonas syringae. Mol. Genet. Genom. 2002, 266, 973–978. [Google Scholar]
- Weber, E.; Koebnik, R. Domain Structure of HrpE, the Hrp Pilus Subunit of Xanthomonas campestris pv. vesicatoria. J. Bacteriol. 2005, 187, 6175–6186. [Google Scholar] [CrossRef]
- Alfano, J.R.; Collmer, A. The type III (Hrp) secretion pathway of plant pathogenic bacteria: Trafficking harpins, Avr proteins, and death. J. Bacteriol. 1997, 179, 5655–5662. [Google Scholar] [CrossRef]
- Granato, L.M.; Picchi, S.C.; De Oliveira Andrade, M.; Takita, M.A.; De Souza, A.A.; Wang, N.; MacHado, M.A. The ATP-dependent RNA helicase HrpB plays an important role in motility and biofilm formation in Xanthomonas citri subsp. Citri. BMC Microbiol. 2016, 16, 55. [Google Scholar] [CrossRef]
- Wang, X.; Yue, J.; Ding, C.; Wang, S.; Liu, B.; Tian, M.; Yu, S. Deletion of AS87-03730 gene changed the bacterial virulence and gene expression of Riemerella anatipestifer. Sci. Rep. 2016, 6, 1–9. [Google Scholar]
- Ji, Z.; Song, C.; Lu, X.; Wang, J. Two coiled-coil regions of Xanthomonas oryzae pv. oryzae harpin differ in oligomerization and hypersensitive response induction. Amino Acids 2011, 40, 381–392. [Google Scholar] [CrossRef] [PubMed]
- Brown, I.R.; Mansfield, J.W.; Taira, S.; Roine, E.; Romantschuk, M. Immunocytochemical localization of HrpA and HrpZ supports a role for the Hrp pilus in the transfer of effector proteins from Pseudomonas syringae pv. tomato across the host plant cell wall. Mol. Plant. Microbe. Interact. 2001, 14, 394–404. [Google Scholar] [CrossRef]
- Haapalainen, M.; Engelhardt, S.; Küfner, I.; Li, C.M.; Nürnberger, T.; Lee, J.; Romantschuk, M.; Taira, S. Functional mapping of harpin HrpZ of Pseudomonas syringae reveals the sites responsible for protein oligomerization, lipid interactions and plant defence induction. Mol. Plant Pathol. 2011, 12, 151–166. [Google Scholar] [CrossRef] [PubMed]
- Cambronne, E.D.; Roy, C.R. Recognition and delivery of effector proteins into eukaryotic cells by bacterial secretion systems. Traffic 2006, 7, 929–939. [Google Scholar] [CrossRef] [PubMed]
- Nguyen, H.P.; Chakravarthy, S.; Velásquez, A.C.; McLane, H.L.; Zeng, L.; Nakayashiki, H.; Park, D.-H.; Collmer, A.; Martin, G.B. Methods to Study PAMP-Triggered immunity using tomato and Nicotiana benthamiana. Mol. Plant-Microbe Interact. 2010, 23, 991–999. [Google Scholar] [CrossRef] [PubMed]
- Li, R.; Wang, S.; Sun, R.; He, X.; Liu, Y. Xanthomonas oryzae pv. oryzae type III effector PthXo3 JXOV suppresses innate immunity, induces susceptibility and binds to multiple targets in rice. FEMS Microbiol. Lett. 2018, 365, fny037. [Google Scholar] [CrossRef] [PubMed]
- Dong, H.; Delaney, T.P.; Bauer, D.W.; Beer, S.V. Harpin induces disease resistance in Arabidopsis through the systemic acquired resistance pathway mediated by salicylic acid and the NIM1 gene. Plant J. 1999, 20, 207–215. [Google Scholar] [CrossRef] [PubMed]
- Choi, M.; Kim, W.; Lee, C.; Oh, C.; Resources, E.N.; Hee, K. Harpins, Multi-functional proteins secreted by gram-negative plant pathogenic bacteria. Mol. Plant-Microbe Interact. 2013, 26, 1115–1122. [Google Scholar] [CrossRef]
- Chen, L.; Qian, J.; Qu, S.; Long, J.; Yin, Q.; Zhang, C.; Wu, X.; Sun, F.; Wu, T.; Hayes, M.; et al. Identification of specific fragments of HpaG Xooc, a Harpin from Xanthomonas oryzae pv. oryzicola, that induce disease resistance and enhance growth in plants. Phytopathology 2008, 98, 781–791. [Google Scholar] [CrossRef]
- Sang, S.; Li, X.; Gao, R.; You, Z.; Lü, B.; Liu, P.; Ma, Q.; Dong, H. Apoplastic and cytoplasmic location of harpin protein Hpa1 Xoo plays different roles in H2O2 generation and pathogen resistance in Arabidopsis. Plant Mol. Biol. 2012, 79, 375–391. [Google Scholar] [CrossRef] [PubMed]
- Boller, T.; Felix, G. A renaissance of elicitors: Perception of microbe-associated molecular patterns and danger signals by pattern-recognition receptors. Annu. Rev. Plant Biol. 2009, 60, 379–406. [Google Scholar] [CrossRef] [PubMed]
- Chisholm, S.T.; Coaker, G.; Day, B.; Staskawicz, B.J. Host-microbe interactions: Shaping the evolution of the plant immune response. Cell 2006, 124, 803–814. [Google Scholar] [CrossRef] [PubMed]
- Tian, S.; Wang, X.; Li, P.; Wang, H.; Ji, H.; Xie, J.; Qiu, Q.; Shen, D.; Dong, H. Plant aquaporin AtPIP1;4 Links Apoplastic H2O2 induction to disease immunity pathways. Plant Physiol. 2016, 171, 1635–1650. [Google Scholar] [CrossRef]
- Li, Y.; Che, Y.; Zou, H.; Cui, Y.; Guo, W.; Zou, L.; Biddle, E.M.; Yang, C.; Chen, G. Hpa2 Required by HrpF to translocate Xanthomonas oryzae transcriptional activator-like effectors into rice for pathogenicity. Appl. Environ. Microbiol. 2011, 77, 3809–3818. [Google Scholar] [CrossRef]
- Li, P.; Zhang, L.; Mo, X.; Ji, H.; Bian, H.; Hu, Y.; Majid, T.; Pang, H.; Tao, Y.; Dong, H. Aquaporin PIP1;3 of rice and harpin Hpa1 of bacterial blight pathogen cooperate in a type III effector translocation. J. Exp. Botony 2019, 70, 3057–3073. [Google Scholar] [CrossRef]
- Wang, X.; Zhang, L.; Ji, H.; Mo, X.; Li, P.; Wang, J.; Dong, H. Hpa1 is a type III translocator in Xanthomonas oryzae pv. Oryzae. BMC Microbiol. 2018, 18, 105. [Google Scholar] [CrossRef]
- Tahir, H.A.S.; Gu, Q.; Wu, H.; Niu, Y.; Huo, R.; Gao, X. Bacillus volatiles adversely affect the physiology and ultra-structure of Ralstonia solanacearum and induce systemic resistance in tobacco against bacterial wilt. Sci. Rep. 2017, 7, 1–15. [Google Scholar] [CrossRef]
- van Gijsegem, F.; Gough, C.; Zischek, C.; Niqueux, E.; Arlat, M.; Genin, S.; Barberis, P.; German, S.; Castello, P.; Boucher, C. The hrp gene locus of Pseudomonas solanacearum, which controls the production of a type III secretion system, encodes eight proteins related to components of the bacterial flagellar biogenesis complex. Mol. Microbiol. 1995, 15, 1095–1114. [Google Scholar] [CrossRef]
- Fernández-Crespo, E.; Navarro, J.A.; Serra-Soriano, M.; Finiti, I.; García-Agustín, P.; Pallás, V.; González-Bosch, C. Hexanoic acid treatment prevents systemic MNSV movement in cucumis melo plants by priming callose deposition correlating SA and OPDA accumulation. Front. Plant Sci. 2017, 8, 1–15. [Google Scholar] [CrossRef]
- Gottig, N.; Vranych, C.V.; Sgro, G.G.; Piazza, A.; Ottado, J. HrpE, the major component of the Xanthomonas type three protein secretion pilus, elicits plant immunity responses. Sci. Rep. 2018, 8, 1–13. [Google Scholar] [CrossRef] [PubMed]
- Piazza, A.; Zimaro, T.; Garavaglia, B.S.; Ficarra, F.A.; Thomas, L.; Marondedze, C.; Feil, R.; Lunn, J.E.; Gehring, C.; Ottado, J.; et al. The dual nature of trehalose in citrus canker disease: A virulence factor for Xanthomonas citri subsp. citri and a trigger for plant defence responses. J. Exp. Bot. 2015, 66, 2795–2811. [Google Scholar] [CrossRef] [PubMed]
- Livak, K.J.; Schmittgen, T.D. Analysis of relative gene expression data using real-time quantitative PCR and the 2-ΔΔCT method. Methods 2001, 25, 402–408. [Google Scholar] [CrossRef] [PubMed]
- Zubair, M.; Hanif, A.; Farzand, A.; Sheikh, T.M.M.; Khan, A.R.; Suleman, M.; Ayaz, M.; Gao, X. Genetic screening and expression analysis of psychrophilic Bacillus spp. reveal their potential to alleviate cold stress and modulate phytohormones in wheat. Microorganisms 2019, 7, 337. [Google Scholar] [CrossRef] [PubMed]
- Weber, E.; Ojanen-Reuhs, T.; Huguet, E.; Hause, G.; Romantschuk, M.; Korhonen, T.K.; Bonas, U.; Koebnik, R. The type III-dependent Hrp pilus is required for productive interaction of Xanthomonas campestris pv. vesicatoria with pepper host plants. J. Bacteriol. 2005, 187, 2458–2468. [Google Scholar] [CrossRef] [PubMed]
- Petrocelli, S.; Arana, M.R.; Cabrini, M.N.; Casabuono, A.C.; Moyano, L.; Beltramino, M.; Moreira, L.M.; Couto, A.S.; Orellano, E.G. Deletion of pilA, a minor pilin-like gene, from Xanthomonas citri subsp. citri influences bacterial physiology and pathogenesis. Curr. Microbiol. 2016, 73, 904–914. [Google Scholar] [CrossRef]
- Lindgren, P.B.; Peet, R.C.; Panopoulos, N.J. Gene cluster of Pseudomonas syringae pv. “phaseolicola” controls pathogenicity of bean plants and hypersensitivity of nonhost plants. J. Bacteriol. 1986, 168, 512–522. [Google Scholar]
- Tian, D.; Wang, J.; Zeng, X.; Gu, K.; Qiu, C.; Yang, X.; Zhou, Z.; Goh, M.; Luo, Y.; Murata-Hori, M.; et al. The rice TAL effector-dependent resistance protein XA10 triggers cell death and calcium depletion in the endoplasmic reticulum. Plant Cell 2014, 26, 497–515. [Google Scholar] [CrossRef]
- Zhang, H.; Xie, X.; Kim, M.S.; Kornyeyev, D.A.; Holaday, S.; Paré, P.W. Soil bacteria augment Arabidopsis photosynthesis by decreasing glucose sensing and abscisic acid levels in planta. Plant J. 2008, 56, 264–273. [Google Scholar] [CrossRef]
- Park, Y.S.; Dutta, S.; Ann, M.; Raaijmakers, J.M.; Park, K. Promotion of plant growth by Pseudomonas fluorescens strain SS101 via novel volatile organic compounds. Biochem. Biophys. Res. Commun. 2015, 461, 361–365. [Google Scholar] [CrossRef]
- Li, X.; Han, L.; Zhao, Y.; You, Z.; Dong, H.; Zhang, C. Hpa1 harpin needs nitroxyl terminus to promote vegetative growth and leaf photosynthesis in Arabidopsis. J. Biosci. 2014, 39, 127–137. [Google Scholar] [CrossRef] [PubMed]

© 2019 by the authors. Licensee MDPI, Basel, Switzerland. This article is an open access article distributed under the terms and conditions of the Creative Commons Attribution (CC BY) license (http://creativecommons.org/licenses/by/4.0/).
Share and Cite
Sheikh, T.M.M.; Zhang, L.; Zubair, M.; Hanif, A.; Li, P.; Farzand, A.; Ali, H.; Bilal, M.S.; Hu, Y.; Chen, X.; et al. The Type III Accessory Protein HrpE of Xanthomonas oryzae pv. oryzae Surpasses the Secretion Role, and Enhances Plant Resistance and Photosynthesis. Microorganisms 2019, 7, 572. https://doi.org/10.3390/microorganisms7110572
Sheikh TMM, Zhang L, Zubair M, Hanif A, Li P, Farzand A, Ali H, Bilal MS, Hu Y, Chen X, et al. The Type III Accessory Protein HrpE of Xanthomonas oryzae pv. oryzae Surpasses the Secretion Role, and Enhances Plant Resistance and Photosynthesis. Microorganisms. 2019; 7(11):572. https://doi.org/10.3390/microorganisms7110572
Chicago/Turabian StyleSheikh, Taha Majid Mahmood, Liyuan Zhang, Muhammad Zubair, Alvina Hanif, Ping Li, Ayaz Farzand, Haider Ali, Muhammad Saqib Bilal, Yiqun Hu, Xiaochen Chen, and et al. 2019. "The Type III Accessory Protein HrpE of Xanthomonas oryzae pv. oryzae Surpasses the Secretion Role, and Enhances Plant Resistance and Photosynthesis" Microorganisms 7, no. 11: 572. https://doi.org/10.3390/microorganisms7110572
APA StyleSheikh, T. M. M., Zhang, L., Zubair, M., Hanif, A., Li, P., Farzand, A., Ali, H., Bilal, M. S., Hu, Y., Chen, X., Song, C., Dong, H., & Zhang, M. (2019). The Type III Accessory Protein HrpE of Xanthomonas oryzae pv. oryzae Surpasses the Secretion Role, and Enhances Plant Resistance and Photosynthesis. Microorganisms, 7(11), 572. https://doi.org/10.3390/microorganisms7110572

